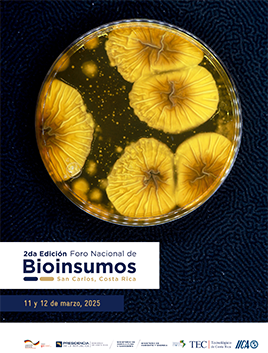

MINISTERIO DE AGRICULTURA Y GANADERÍA DE COSTA RICA
Institución rectora del sector agropecuario que impulsa su desarrollo sostenible, equitativo y competitivo.
Somos el aliado estratégico de productores y familias rurales, enfocados en la innovación tecnológica para la productividad avanzada y la prosperidad de las cadenas de valor del país.
#SomosAgroCR
Instituciones del Sector Público Agropecuario
Servicio Fitosanitario del Estado
Instituto Nacional de Innovación y Transferencia en Tecnología Agropecuaria
Servicio Nacional de Aguas Subterráneas Riego y Avenamiento
Secretaría Ejecutiva de Planificación Sectorial Agropecuaria
2105 6100 ext. 1352 direccionsepsa@mag.go.cr www.sepsa.go.cr